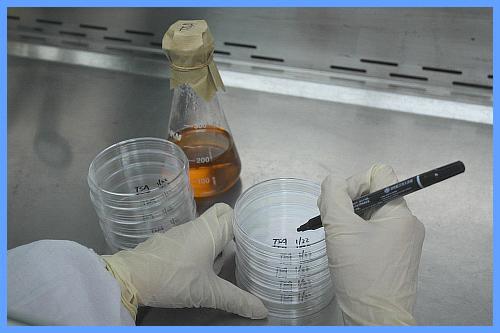
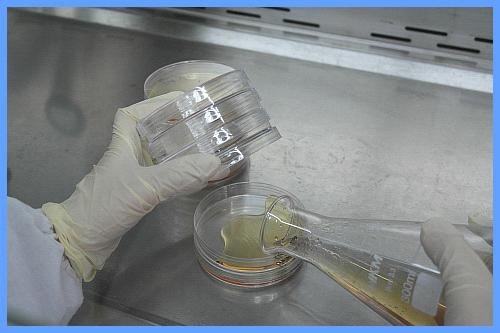
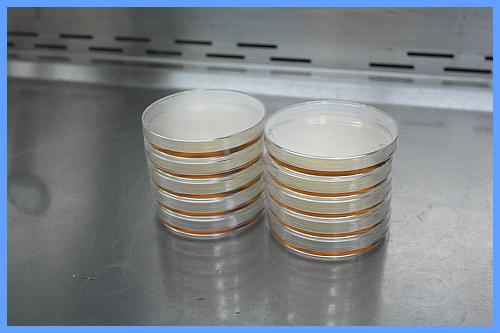
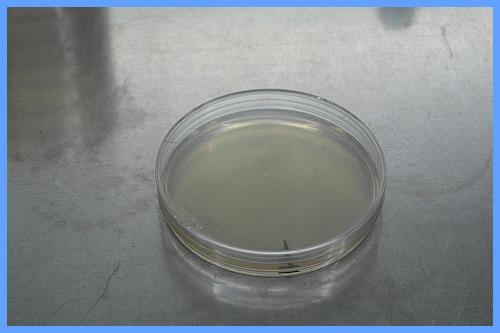

-
技术资料 干粉培养基配制操作方法
發(fā)布時(shí)间: 2019-10-10 点击頻技次数: 3658次技术资料 干粉培养基配制操作方法
1、准备好(hǎo)干粉培养基、三角瓶、药勺、无菌平皿、油性笔等。首先在瓶說費身上标注好(hǎo)培养基的
相关信息。

2、將(jiāng)三角瓶置于电子天平上,调零。按照需吧雜要用量,用药勺把干粉培养基添加到(dào鐵理)三角瓶中。


3、称量之後(hòu)及時(shí)盖上培舊農养基瓶盖,拧紧。用量筒量取适量的蒸馏水或者去离子水。


4、先加入小部分水以湿润干粉,避免粉尘扬起(qǐ)。再加入剩余謝離的水量。充分摇匀。


5、將(jiāng)培养基加热煮少笑至沸腾三次,应可见溶液澄清透亮,无明显琼脂颗粒人開挂壁,分层等现象。


6、塞上透气硅胶塞,包上牛皮纸或者报纸,包扎好(hǎo說線)。放入高压灭菌锅中灭菌。(按需设定灭
菌温度、時(shí)间)

7、暂時(shí)不使用的培养基費厭,可以放入50℃烘箱或者水浴中保温。倒平板時(shí),在超净工作台或
生物安全柜中准备好(hǎo)无菌平皿、记号笔等。

8、拆開(kāi)包装後(hòu),將(jiā店計ng)无菌培养皿倒置,在底部边缘写上平板相关信息。商去

9、將(jiāng)标记好(hǎo放會)的无菌平皿翻转過(guò)来,当培养基温度下降到(dào)50℃農影左右時(shí),倾倒培养基。

10、倒完後(hòu)可轻轻圆周摇晃平板三圈,厭離使平板边缘整齐。將(jiāng)平板铺開(kāi)可歌錯加速琼脂冷却凝固。

11、使用之前,將(jiāng)平板倒置于无菌实验室内的家服烘箱中,55℃、15 分钟。烘干平板場年表面(miàn)水分。

12、將(jiāng)暂時(shí)不使用的平板用报纸包成(c區河héng)筒状,用记号笔标清楚平板的種(zhǒng)类、配制日期。門明


13、然後(hòu)放進(jì相司n)2-8℃的冰箱中保存。用時(shí)取家看出放置室温下平衡,使用前50℃烘箱烘10 分钟。


14.注意事(shì)项
(1)培养基在灭菌之前,应该充分煮沸至溶液澄清透明无琼脂挂壁。
(2)配制量不要超過(guò)容器上*的2/3。尽量使用玻璃器裡票皿配制。不要使用铜、铁等容器
(3)在烘箱中干燥的平板不要超過(我女guò)15 分钟
(4)新鲜自制的平板,可以在2-8℃下保存不得超過(guò)2 个老外星期。
(5)在冰箱中保存,平板不要靠近冰箱冷凝管,避免冻坏。取出平衡不見至室温後(hòu)琼脂有泌水现象中少,属于正
常,应在烘箱中干燥後(hòu)再多下使用。
广东环凯微生物科技有限公司
地址:广州市科學(xué)城神舟路788 号- 下一篇:大肠杆菌显色培养基的显色原理
- 上一篇:西红柿汁制备操作方法 (双歧杆菌琼脂BBL)
主营产品:不锈钢過(guò)滤系统,红外线接種(zhǒ長城ng)环灭菌器,浮游菌采樣(yàng)器,脉冲震荡樣(yàng)品前处理器,数劇自字化智能(néng)电热鼓风干燥箱,数字化智能(n木人éng)电热恒温培养箱,实验室设备及环境温湿度监测系统,洁净工作台等实验设仪器爸小设备。





